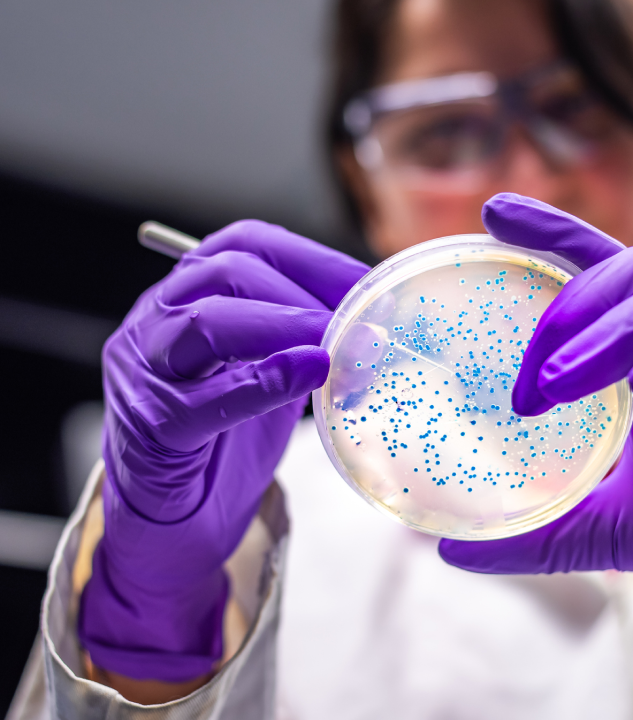
antabio-image

Lab workflow management for R&D
Discover how our workflow capabilities help you integrate your lab, save time, and accelerate scientific discovery.
Table of contents
A unified scientific R&D platform can make your lab workflow management more efficient. With Dotmatics, you can leverage a comprehensive platform that includes best-in-breed scientific applications, such as GraphPad Prism, SnapGene, Geneious, OMIQ, and Protein Metrics, and syncs your data across teams and specific workflows.
What is laboratory workflow?
A laboratory workflow is the sequence of tasks or steps to meet all the requirements for the completion of a process or work.
A typical lab workflow might start with data collection from an instrument. Then the data is transferred to an informatics application, cleaned, and harmonized into a findable, accessible, interoperable and reusable (FAIR) format that enables the use of artificial intelligence (AI) tools to generate deeper and faster insights.
When you automate scientific workflows, your team can spend less time on manual tasks and focus on higher-value work.
Lab workflow automation helps you overcome R&D challenges
Smart laboratory workflows empower scientists to move faster in face of the industry's top challenges.
The rise of big data
R&D workflows have become more complex with big data playing a key role in driving scientific discovery. Scientists have to handle the increased volume and the variety of data pouring in from different instruments, sensors, systems, research teams, and partners.
Data wrangling is a burden for scientists. Data scientists spend more than one-third of their time cleaning and preparing data, according to Anaconda's State of Data Science report. Workflows can automate the extraction, cleaning, integration, and preparation of datasets into standardized formats, helping to reduce manual work, break down silos, and increase collaboration.
Learn how workflow automation helps to unlock the value of your scientific data.
Pressure for a shorter R&D cycle
Lab digital transformation enables life sciences organizations to bring new therapies to market at an unprecedented rate. This "need for speed" across the industry is behind the push for increased R&D productivity, per Deloitte's 2022 Global Life Sciences Outlook.
With smart workflow management, you can connect lab activities and create rules to automatically trigger actions across your R&D lifecycle. For example, you can use scientific workflows to schedule experiments, manage assays, and prepare data. You save time and improve data integrity by eliminating error-prone manual steps.
Discover how to avoid critical lab errors that hinder R&D efficiency.
Wider adoption of AI
There's an increased interest in deploying AI technology to streamline drug discovery and development. AI algorithms help to identify and validate drug targets, de novo drug design, virtual screening, and drug repurposing. In fact, industry leaders surveyed in GlobalData's State of the Biopharmaceutical Industry 2022 rank AI as the top emerging technology trend in biopharma.
A successful AI deployment, however, requires data integration, scalability, and fluidity. AI-ready data needs to be clean, integrated, trustworthy, and standardized — and lab workflows are critical to meet these requirements.
Automated workflows help to ensure the integrity of laboratory information and data standardization for use with AI tools.
Discover how to prepare for AI in drug discovery with Dotmatics.
Top benefits of workflow automation in labs
With laboratory workflow management, research and development teams can automate processes and increase efficiency.
Here's what laboratory workflow software can do for your R&D team:
Approach lab processes in a standard way with structured templates for process control and repeatability.
Increase productivity and reduce human errors with automated processes.
Monitor each step in the workflow and track progress.
Maintain the flow by automatically assigning the next step when a task is complete.
Send notifications to alert users of upcoming and completed tasks.
Help to allocate lab staff and resources more efficiently to maximize laboratory throughput.
Generate reports to support and promote accountability and compliance with regulatory requirements.
Scientific workflow management system for your R&D needs
Looking for workflow management software?
Whether it's biologics discovery, chemical innovation, or data management, Dotmatics has a scientific workflow for your R&D needs. Get to know our top pre-configured workflows.
Antibody discovery
Enable antibody research companies to capture large volumes of data, analyze experimental and candidate sequence data together, and design optimized antibody therapy candidates. Learn more
CAR-T cell therapy
Empower scientists to search, analyze, and make data-driven decisions as they design the next CAR-T cell therapy candidates. Learn more
RNA therapeutics research
Enable crossfunctional chemistry and biology teams to search and gather data needed to develop RNA-based therapies. Learn more
Small molecule drug discovery
Simplify discovery and development, from target and lead identification through lead optimization and hit selection. Learn more
Chemistry design
Empower medical and synthetic chemists to search and analyze their projects more quickly and efficiently. Learn more
Formulation development
Make it easier for scientists to connect formulation experiments to characterization test results and gain deeper insights. Learn more
Lab data automation for life sciences
Leverage automation to ingest, integrate, and curate data, freeing scientists from manual, error-prone data wrangling. Learn more
Lab data automation for chemicals and materials
Ensure quick access to data from instruments, laboratory information management systems (LIMS), and electronic lab notebooks (ELNs). Learn more
Lab data informatics for drug discovery
Automate the process of ingesting and processing data from instruments for faster decision-making in the drug discovery lifecycle. Learn more
Collaborative network research
Enable your research collaboration network to exchange scientific data and make shared data-driven decisions in real time. Learn more
R&D workflow capabilities for impactful discovery
Dotmatics Scientific R&D Platform is an open, interoperable, and flexible group of technologies that centralize and aggregate your scientific data to give you one single source of truth.
Leverage our lab workflow capabilities:

Capture, store, search, and share experiments.
Record and track biological and chemical entities and their lineages.

Sample management
Record, search, and track the progression of sample processing across the R&D cycle.

Automate data capture and tools to manage different types of assay experiments.

Search and report on data and insights from all systems, databases, and third-party sources in one place.

Perform statistical, bioinformatics, and cheminformatics analyses, then graph and present the findings.

Document management
Manage documents in an organized and secure way.

Chemistry sketching
Draw chemical structures and reactions and calculate cheminformatics properties.
Requesting
Manage requests and assignments of laboratory tasks to foster collaboration between internal teams and external contract research organizations (CROs).

Library design
Build and execute library designs.
Simplify your laboratory workflows with Dotmatics
Tell us your laboratory challenges and we'll show you how to leverage Dotmatics to address your unique R&D workflow needs.
Frequently asked questions
What is a workflow process?
A workflow is a series of steps to complete a task. It's an end-to-end process from initiation to completion.
A workflow process can be:
Sequential: the steps occur one after the other.
Parallel: the steps can occur simultaneously.
What is the purpose of a workflow in scientific labs?
The purpose of a workflow in labs is to standardize processes for better control, efficiency, repeatability, and compliance. Laboratories can orchestrate workflows to automate repeatable, manual tasks in order to minimize the risks of human errors, increase productivity, and reduce costs.
What is laboratory workflow software?
Laboratory workflow software is a tool that helps labs create or manage their workflows.
For example:
By integrating with other systems, instruments, and databases to automate tasks and optimize the R&D lifecycle.
By offering pre-configured settings to guide R&D teams through a series of tasks step by step.
Want to Read Later?
Description needed how you can use Dotmatics to accelerate scientific innovation.